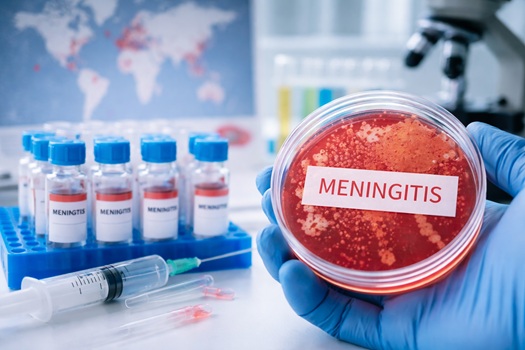

Estudo aponta mais de 250 mil mortes em 2023 e alerta para desaceleração na redução da doença, apesar de avanços históricos com vacinas
Por Paloma de Sá | GNEWSUSA
O combate mundial à meningite enfrenta um novo desafio: a desaceleração no ritmo de queda de casos e mortes pode impedir o cumprimento das metas estabelecidas pela Organização Mundial da Saúde (OMS) até 2030. A conclusão é de um amplo levantamento publicado na revista científica The Lancet Neurology, que analisou dados globais entre 1990 e 2023.
Segundo o estudo, mais de 250 mil pessoas morreram em decorrência da meningite apenas em 2023, enquanto cerca de 2,5 milhões contraíram a doença no mesmo período. Apesar de uma redução expressiva de 63,5% na taxa de mortalidade nas últimas três décadas, os números ainda estão acima dos objetivos definidos pela OMS.
Lançada em 2021, a estratégia global da OMS estabelece metas ambiciosas: eliminar epidemias de meningite bacteriana, reduzir em 50% os casos evitáveis por vacinação e cortar em 70% o número de mortes. No entanto, os dados mais recentes indicam que o avanço perdeu força nos últimos anos.
Entre 2015 e 2023, a queda na mortalidade foi de apenas 25,4%, com uma redução média anual de 4,1%. O índice é praticamente metade do necessário para atingir as metas globais, que exigiriam uma diminuição de cerca de 8% ao ano nas mortes e 4,6% na incidência da doença.
Especialistas apontam que o progresso mais acelerado registrado nas décadas anteriores foi impulsionado principalmente por campanhas de vacinação em larga escala. Esses esforços foram decisivos para controlar sorotipos específicos de bactérias, como a Neisseria meningitidis, especialmente em regiões de alto risco.
Entretanto, novos desafios vêm comprometendo esse avanço. O surgimento de cepas não cobertas pelas vacinas atuais e o aumento da resistência aos antibióticos têm dificultado o controle da doença. Além disso, fatores estruturais, como desigualdade no acesso à saúde e baixa cobertura vacinal em países mais pobres, agravam o cenário.
As crianças menores de cinco anos continuam sendo o grupo mais vulnerável. Em 2023, foram registradas aproximadamente 86,6 mil mortes nessa faixa etária, o que representa mais de um terço dos óbitos globais. Entre os fatores de risco estão baixo peso ao nascer, prematuridade e exposição à poluição do ar.
Outro ponto crítico é a persistência de altos índices de meningite na chamada “cintura africana da meningite”, região que se estende do Senegal à Etiópia. Países como Nigéria, Chade e Níger concentram algumas das maiores taxas de incidência e mortalidade, especialmente durante períodos de seca, quando surtos são mais frequentes.
Para especialistas, o cenário exige uma resposta global mais robusta. Entre as estratégias consideradas essenciais estão a ampliação da cobertura vacinal, o desenvolvimento de novas vacinas mais abrangentes, o uso racional de antibióticos e o fortalecimento dos sistemas de vigilância e diagnóstico precoce.
A meningite é uma doença grave que pode causar sequelas permanentes, como perda auditiva, comprometimento neurológico e dificuldades motoras. A transmissão ocorre principalmente por gotículas respiratórias, como tosse e espirro, o que facilita sua disseminação, especialmente em ambientes com alta densidade populacional.
No Brasil, a imunização segue como principal forma de prevenção, com vacinas disponíveis pelo sistema público contra diferentes agentes causadores da doença, incluindo meningococo, pneumococo e Haemophilus influenzae tipo B.
Diante da desaceleração observada, especialistas alertam que o mundo está em um momento decisivo: sem intensificação das ações de prevenção e controle, a meningite pode continuar representando uma ameaça significativa à saúde global, especialmente entre populações mais vulneráveis.
- Leia mais:
https://gnewsusa.com/2026/03/alemanha-vence-gana-e-ganha-confianca-as-vesperas-da-convocacao-final/
https://gnewsusa.com/2026/03/governo-chileno-interrompe-processo-de-legalizacao-de-estrangeiros/


Faça um comentário